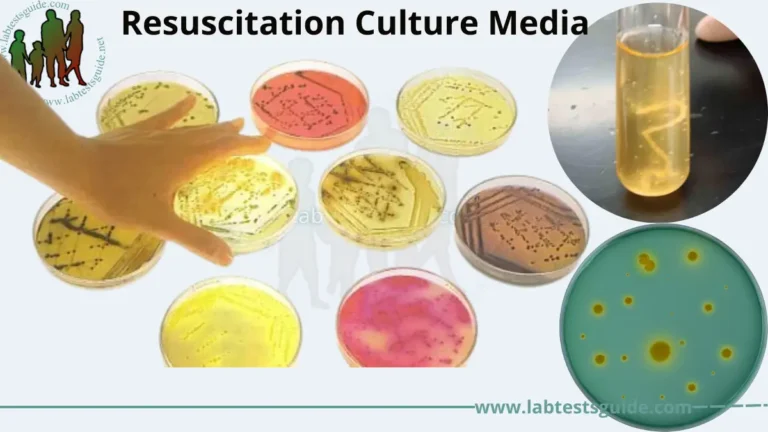
Resuscitation Culture Media

Enrichment Culture media are liquid media that also serves to inhibit commensals in the clinical specimen. Selenite F broth, tetrathionate broth and alkaline peptone water are used to recover pathogens from fecal specimens. Selectively allows certain organism to grow and inhibit others. Eg- Tetrathionate broth (S. Typhi), Alkaline peptone water broth (APW)- Vibrio, Selenite F broth-Shigella

Basics:
- Basic principle is to control the nutrients and culture conditions in such a way that it suits mainly to a specific species
- temperature, air supply, light, pH
- When we assume low amount of potential pathogens being present in the specimen, they have to be enriched first, to multiply up the low number โ e.g. serum bouillon, dextrose bouillon, chopped meat bouillon
- Promotes the growth of a particular organism by providing it with the essential nutrients, and rarely contains inhibitory substances to prevent the growth of normal competitors
Principle And Interpretation:
Enriched media contain the nutrients required to support the growth of a wide variety of organisms, including some of the more fastidious ones. They are commonly used to harvest as many different types of microbes as are present in the specimen(1). Enrichment medium is general purpose enrichment agar which can nourish and support the growth of gram-positive as well as gram-negative bacteria. It can also be supplemented with blood for enriched growth or study the haemolysis. This medium contains peptic digest of animal tissue and yeast extract which serves as source of nitrogen, carbon, amino acids, vitamins and growth factors for growth of bacteria. Dipotassium phosphate buffers the medium well. Agar is solidifying agent.
Enrichment Medium is a highly nutritive medium which can be used as a general purpose enrichment agar base.
Composition:
| Ingredients | Gms / Litre |
|---|---|
| Peptic digest of animal tissue | 40.000 |
| Yeast extract | 6.000 |
| Dipotassium phosphate | 3.000 |
| Agar | 15.000 |
| Final pH ( at 25ยฐC) | 7.0ยฑ0.2 |
Directions: Suspend 64 grams in 1000 ml distilled water. Heat to boiling to dissolve the medium completely. Sterilize by autoclaving at 15 lbs pressure (121ยฐC) for 15 minutes.
Quality Control :
- Appearance: Light yellow coloured homogeneous free flowing powder
- Gelling: Firm, comparable with 1.5% Agar gel
- Colour and Clarity of prepared medium: Light amber coloured clear gel forms in Petri plates.
- Reaction: Reaction of 6.4% w/v aqueous solution at 25ยฐC. pH : 7.0ยฑ0.2
- pH: 6.80-7.20
- Cultural Response: Cultural characteristics observed after an incubation at 35 – 37ยฐC after 24 hours
Types of Culture Media :
There are some types of important culture or growth media used in microbiological laboratories:
- The Preservation Culture Media:
Preservation culture media are nutrient-rich formulations used to store and maintain the viability of microorganisms for extended periods, ensuring their long-term preservation and availability for future use in laboratory settings or culture collections. - The Enrichment Culture Media:
These media contain additional nutrients that are designed to support the growth of fastidious microorganisms. They may also contain growth factors that are essential for the growth of certain organisms. Examples of enriched media include blood agar, chocolate agar, and thioglycollate broth. - Selective Culture Media:
These media contain substances that inhibit the growth of unwanted microorganisms, allowing only the desired organisms to grow. Selective media are often used to isolate specific bacteria from a mixed culture. Examples of selective media include MacConkey agar, Mannitol salt agar, and Eosin methylene blue (EMB) agar. - Differential Culture Media:
These media contain substances that allow the differentiation of different types of microorganisms. Differential media typically contain a pH indicator that changes color in the presence of certain metabolites. Examples of differential media include Triple Sugar Iron (TSI) agar, Kligler’s Iron Agar (KIA), and Simmons citrate agar. - Resuscitation Culture Media:
Resuscitation culture media are used to help revive bacteria that have been stressed or injured by environmental factors. These media typically contain nutrients and growth factors that can help promote the recovery and growth of bacterial cells. - General Purpose Media:
These media are designed to support the growth of a wide variety of microorganisms. They are typically made with a simple nutrient formulation that includes a source of carbon, nitrogen, and energy. Examples of general-purpose media include nutrient broth, nutrient agar, and peptone water. - Transport media:
These media are designed to preserve the viability of microorganisms during transport to a laboratory. Transport media typically contain nutrients and a buffering agent that help to protect the microorganisms from environmental stresses. Examples of transport media include Stuart’s transport medium and Amies transport medium. - Anaerobic media:
These media are designed to support the growth of anaerobic microorganisms. Anaerobic microorganisms require an oxygen-free environment to grow. Anaerobic media typically contain a reducing agent that removes oxygen from the medium. Examples of anaerobic media include Robertson’s cooked meat medium and Thioglycolate broth.

5 Comments